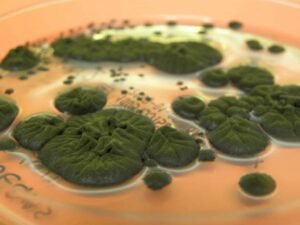

¿Quieres un año de aventura con impacto social? Servicio País 2026 abrió sus postulaciones y paga hasta $700 mil mensuales.
#ContextoExpress
La iniciativa, impulsada por la Fundación Superación de la Pobreza, busca que profesionales y técnicos trabajen durante un año en zonas rurales y apartadas de Chile, aportando en áreas como salud, educación, turismo, construcción y administracióncnnchile.com.
¿Qué pasó?
El programa abrió más de 200 cupos en 95 comunas del país, con inicio en marzo de 2026. Quienes resulten seleccionados podrán elegir hasta tres regiones de preferencia al momento de postular.
El aporte mensual varía entre $600.000 y $700.000, dependiendo de la zona asignada. Además, incluye seguro de salud, pasajes de ida y vuelta y 300 horas de capacitación certificada en políticas públicas, gobiernos locales y trabajo comunitariocnnchile.com.
¿Por qué importa?
Porque más allá del sueldo, Servicio País es una experiencia que conecta a jóvenes con territorios donde el Estado suele llegar tarde. Es un puente entre profesionales urbanos y comunidades rurales, generando cambios reales en el acceso a derechos y servicios básicos. Y para muchos, también es una escuela de vida 🚀.
Datos duros
- Postulaciones abiertas hasta: 31 de octubre de 2025.
- Cupos disponibles: más de 200.
- Comunas beneficiadas: 95 en todo Chile.
- Duración: 1 año (desde marzo 2026).
- Beneficios extra: seguro de salud, pasajes y formación certificada.
#DatazoKulto
Desde su creación en 1995, Servicio País ha movilizado a más de 6.000 profesionales en comunidades aisladas de todo Chile, generando proyectos que van desde alfabetización digital hasta programas de turismo rural.
#GlosarioKulto
- Servicio País: programa chileno que envía profesionales a zonas apartadas para apoyar el desarrollo local.
- Capacitación certificada: formación formal validada por instituciones, en este caso enfocada en políticas públicas y gestión comunitaria.
¿Postularías a un año de trabajo lejos de la ciudad por aportar al desarrollo local?
¿Crees que programas como este deberían expandirse para llegar a más jóvenes y comunas? Debate en #ElCirculo 👇